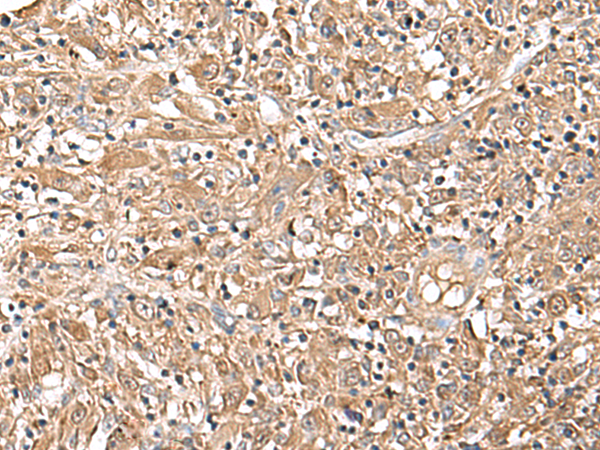

宿 主: Rabbit
|
Background: |
The protein encoded by this gene belongs to the gp130 family of cytokine receptors that are known to stimulate gene transcription via activation of cytosolic STAT proteins. This protein is a receptor for leptin (an adipocyte-specific hormone that regulates body weight), and is involved in the regulation of fat metabolism, as well as in a novel hematopoietic pathway that is required for normal lymphopoiesis. Mutations in this gene have been associated with obesity and pituitary dysfunction. Alternatively spliced transcript variants encoding different isoforms have been described for this gene. It is noteworthy that this gene and LEPROT gene (GeneID:54741) share the same promoter and the first 2 exons, however, encode distinct proteins (PMID:9207021). |
|
Applications: |
ELISA, WB, IHC |
|
Name of antibody: |
LEPR |
|
Immunogen: |
Synthetic peptide of human LEPR |
|
Full name: |
leptin receptor |
|
Synonyms: |
OBR; OB-R; CD295; LEP-R; LEPRD |
|
SwissProt: |
P48357 |
|
ELISA Recommended dilution: |
5000-10000 |
|
IHC positive control: |
Human liver cancer |
|
IHC Recommend dilution: |
40-200 |
|
WB Predicted band size: |
133 kDa |
|
WB Positive control: |
293T cell lysate |
|
WB Recommended dilution: |
500-2000 |

購物車
幫助
021-54845833/15800441009
